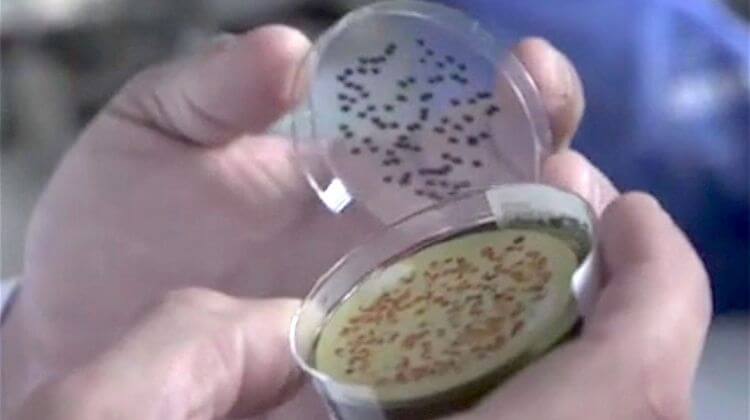
Laboratoires des Pyrénées et des Landes 2

Ce labo de pointe est donc spécialisé en santé environnementale, analysant les prélèvements sanguins pour l’élevage, la potabilité de l’eau, ainsi que la qualité de l’air.
Ici, on chasse les polluants, les résidus de molécules, de pesticides et de médicaments, les bactéries et même les micropolluants dans les eaux usées. Une véritable mission de service public, menée par quelque 350 collaborateurs à Lagor, Mont-de-Marsan et Tarbes, réalisant 19 millions d’euros de chiffre d’affaires.
Les LPL étaient un peu à l’étroit à Lagor, dans des bâtiments devenus vétustes. Alors, dans leurs recherches de nouveaux locaux, ils sont tombés sur les 1600 mètres carrés de l’ex-usine Celanese, fermée en 2009. Une bonne opportunité pour le troisième labo public de France.
Ok, il faudra revoir un peu l’électricité, repenser la déco, mais pour désengorger le siège de Lagor, rien de mieux ! Sans oublier la possibilité de développer de nouvelles activités. A moins de 8 kilomètres de Lagor, le nouveau site de Pardies renfocer son identité.
Il y aura de 300 à 500.000 euros investis dans l’aménagement. Un vrai redémarrage pour LPL qui avait connu des heures difficiles mais dont le déménagement aujourd’hui d’une partie de ses activités confirme le rebond, et la dynamique. Reste à lui trouver un petit nom. Ce sont les salariés des LPL qui devraient s’y coller.
Il faut au moins ça pour le troisième labo public de France.
Informations sur le site internet labopl.com
https://vimeo.com/107791870

Réagissez à cet article
Vous devez être connecté(e) pour poster un commentaire